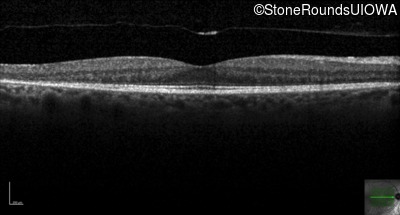
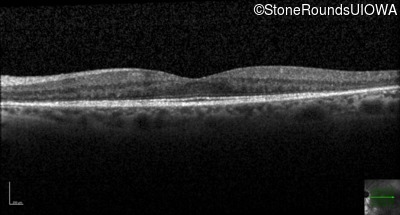
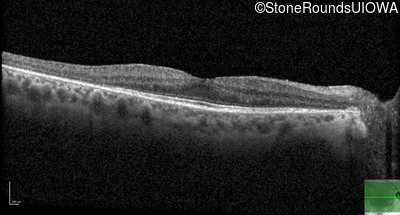
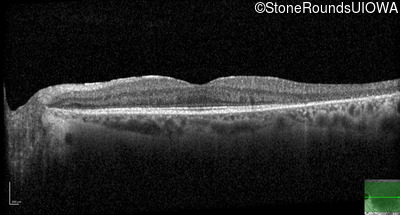

Case
SR68
Student Mode
AD Retinitis Pigmentosa (IA1aii)
Female
Female
Hidden
SR68
Student Mode
AD Retinitis Pigmentosa (IA1aii)
Female
Female
History
This 57 year old woman has had poorer night vision than her friends for her entire life. At age 51, her worsening night vision caused her to seek medical attention. She has always been correctable to 20/20 OU.
| Color Vision: | 14/14 pseudoisochromatic plates OU |
|---|---|
| Refraction OD: | -1.50 +1.00 x 158 |
| Refraction OS: | -1.25 +1.00 x 027 |
Teaching Points
The clinical features supporting the diagnosis of autosomal dominant retinitis pigmentosa in this patient include: night blindness as her earliest symptom; an inferior sector of bone-spicule-like pigmentation and narrowed arterioles on fundus examination; a striking symmetrical superior visual field loss; loss of outer retinal structures on OCT; and, 2 similarly affected aunts, a brother and grandmother.
| Age at visit: 62 years |
Diagnosis & molecular findings
| Disease | Gene | Allele 1 variant(s) | Allele 2 variant(s) | Inheritance mode |
|---|---|---|---|---|
| AD Retinitis Pigmentosa | RHO | Gly106Arg GGG>AGG | AD |